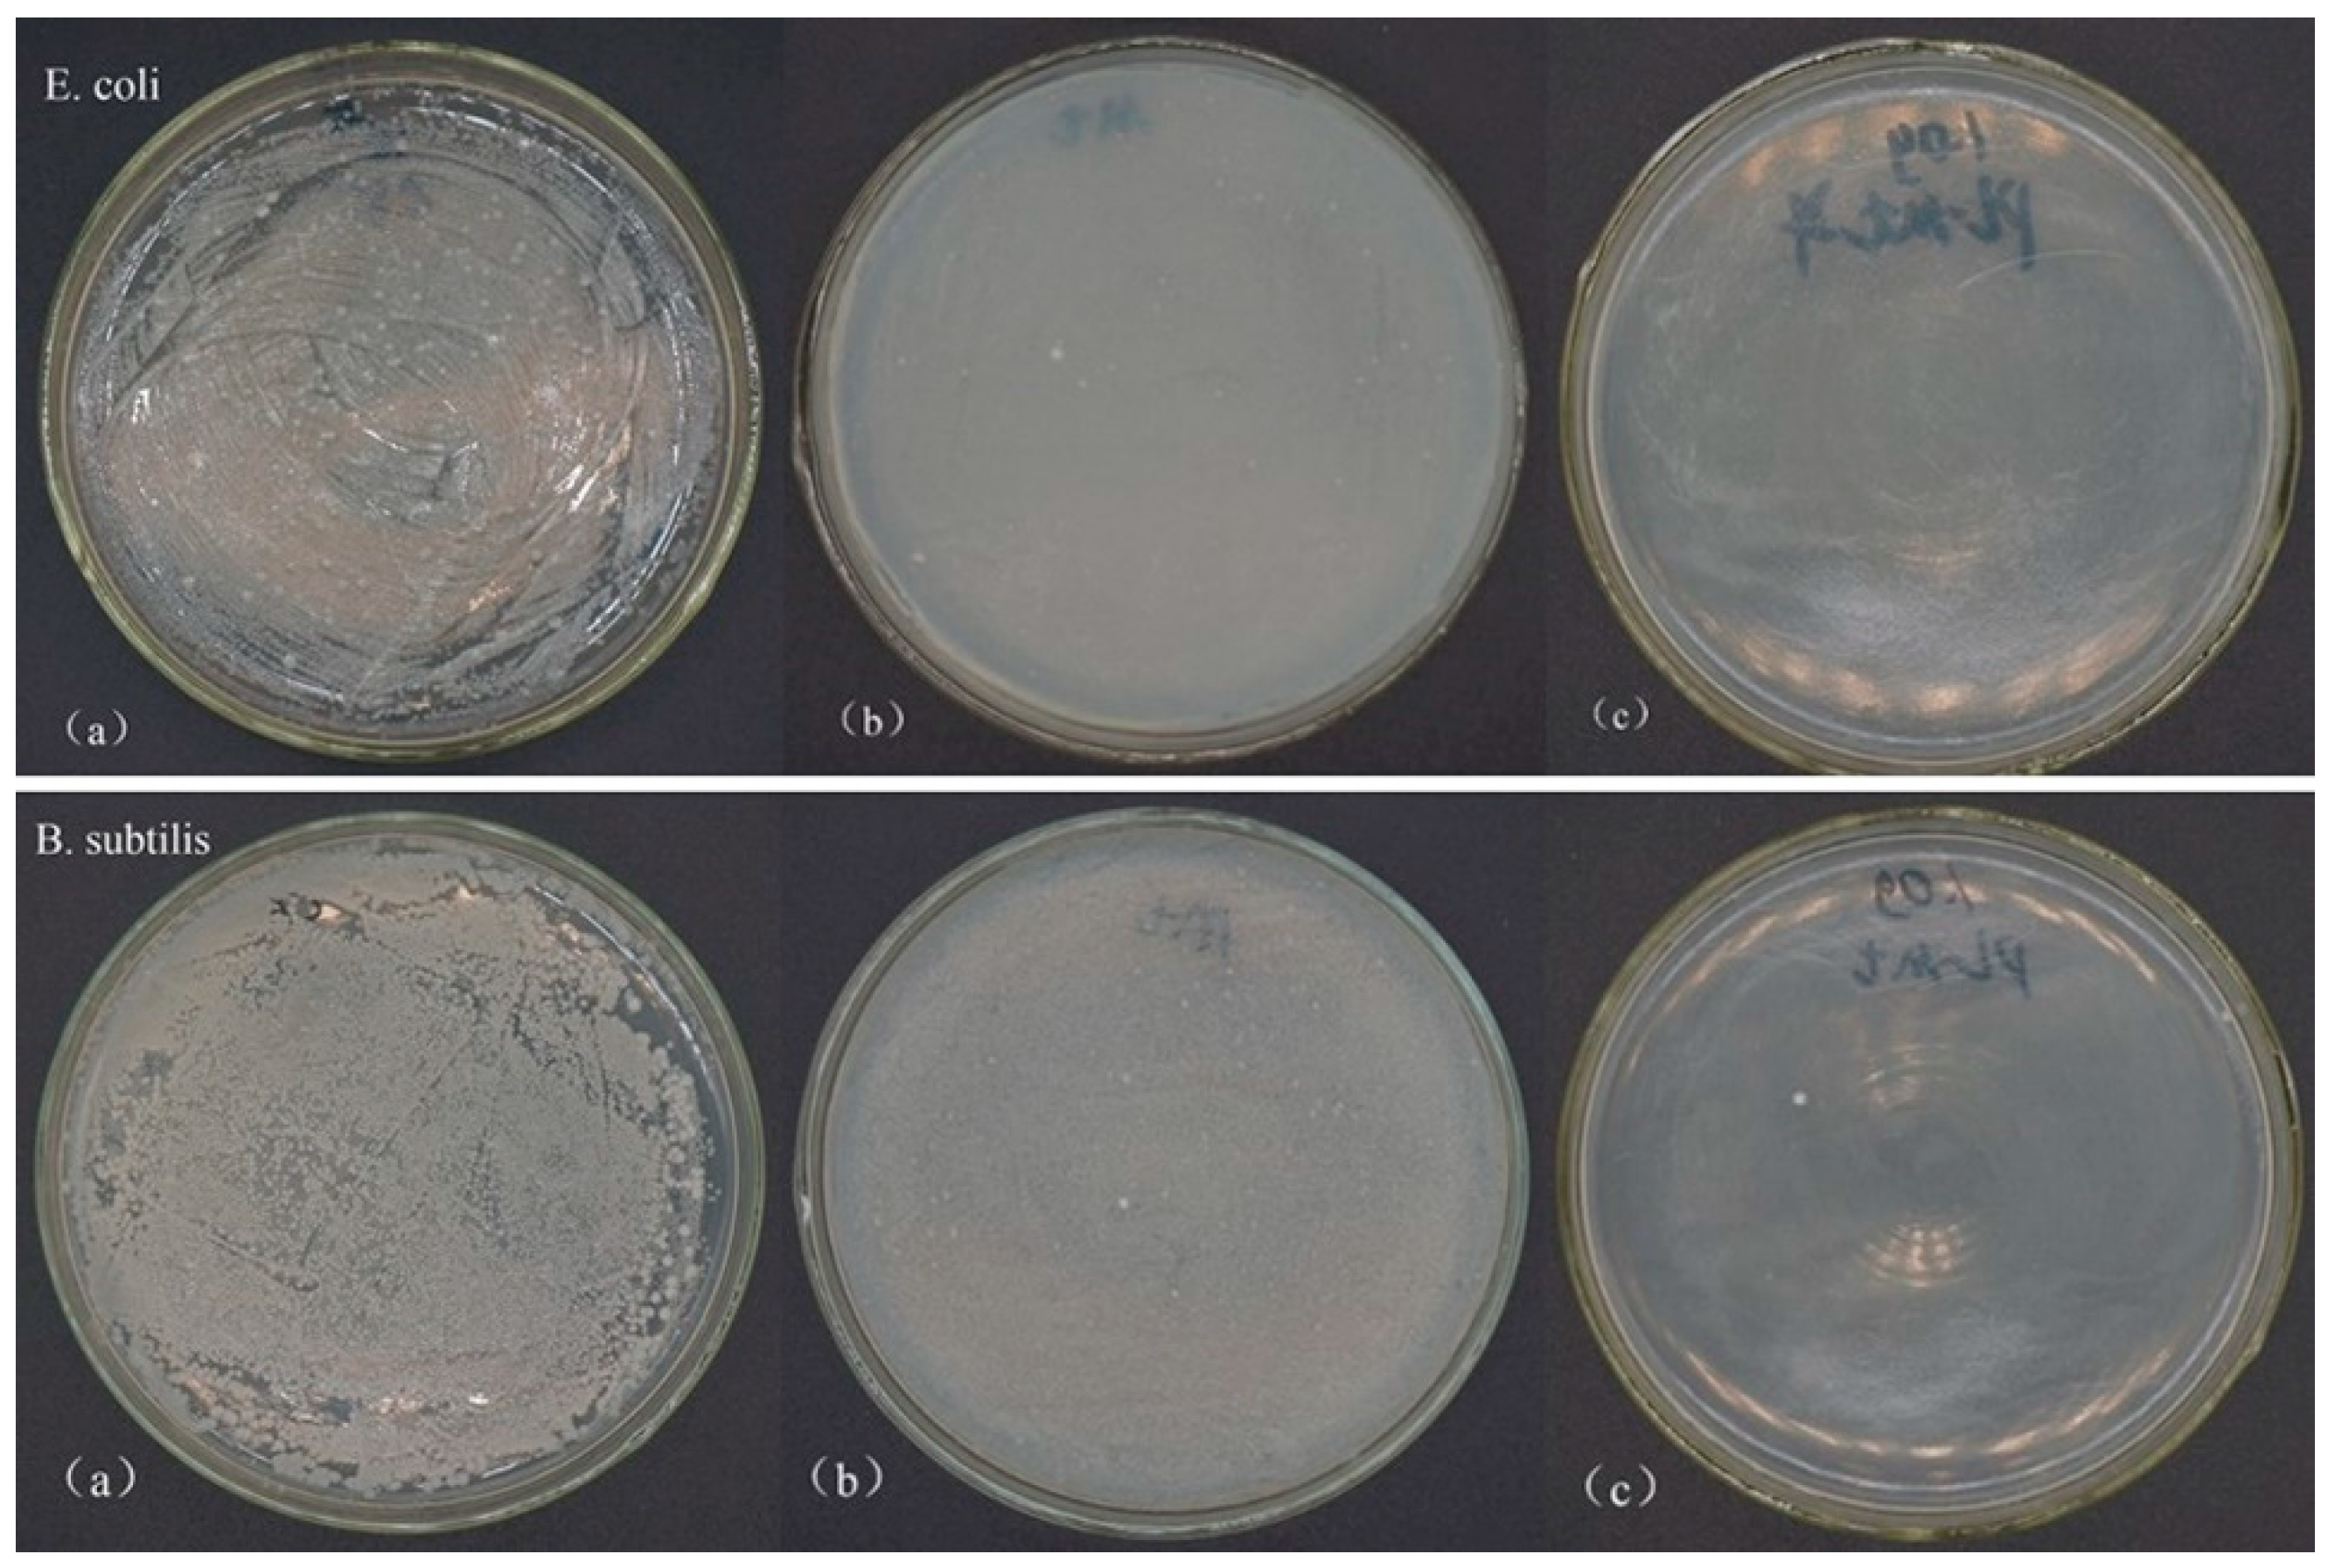
Materials 12 04148 g004 Materials 12 04148 g004
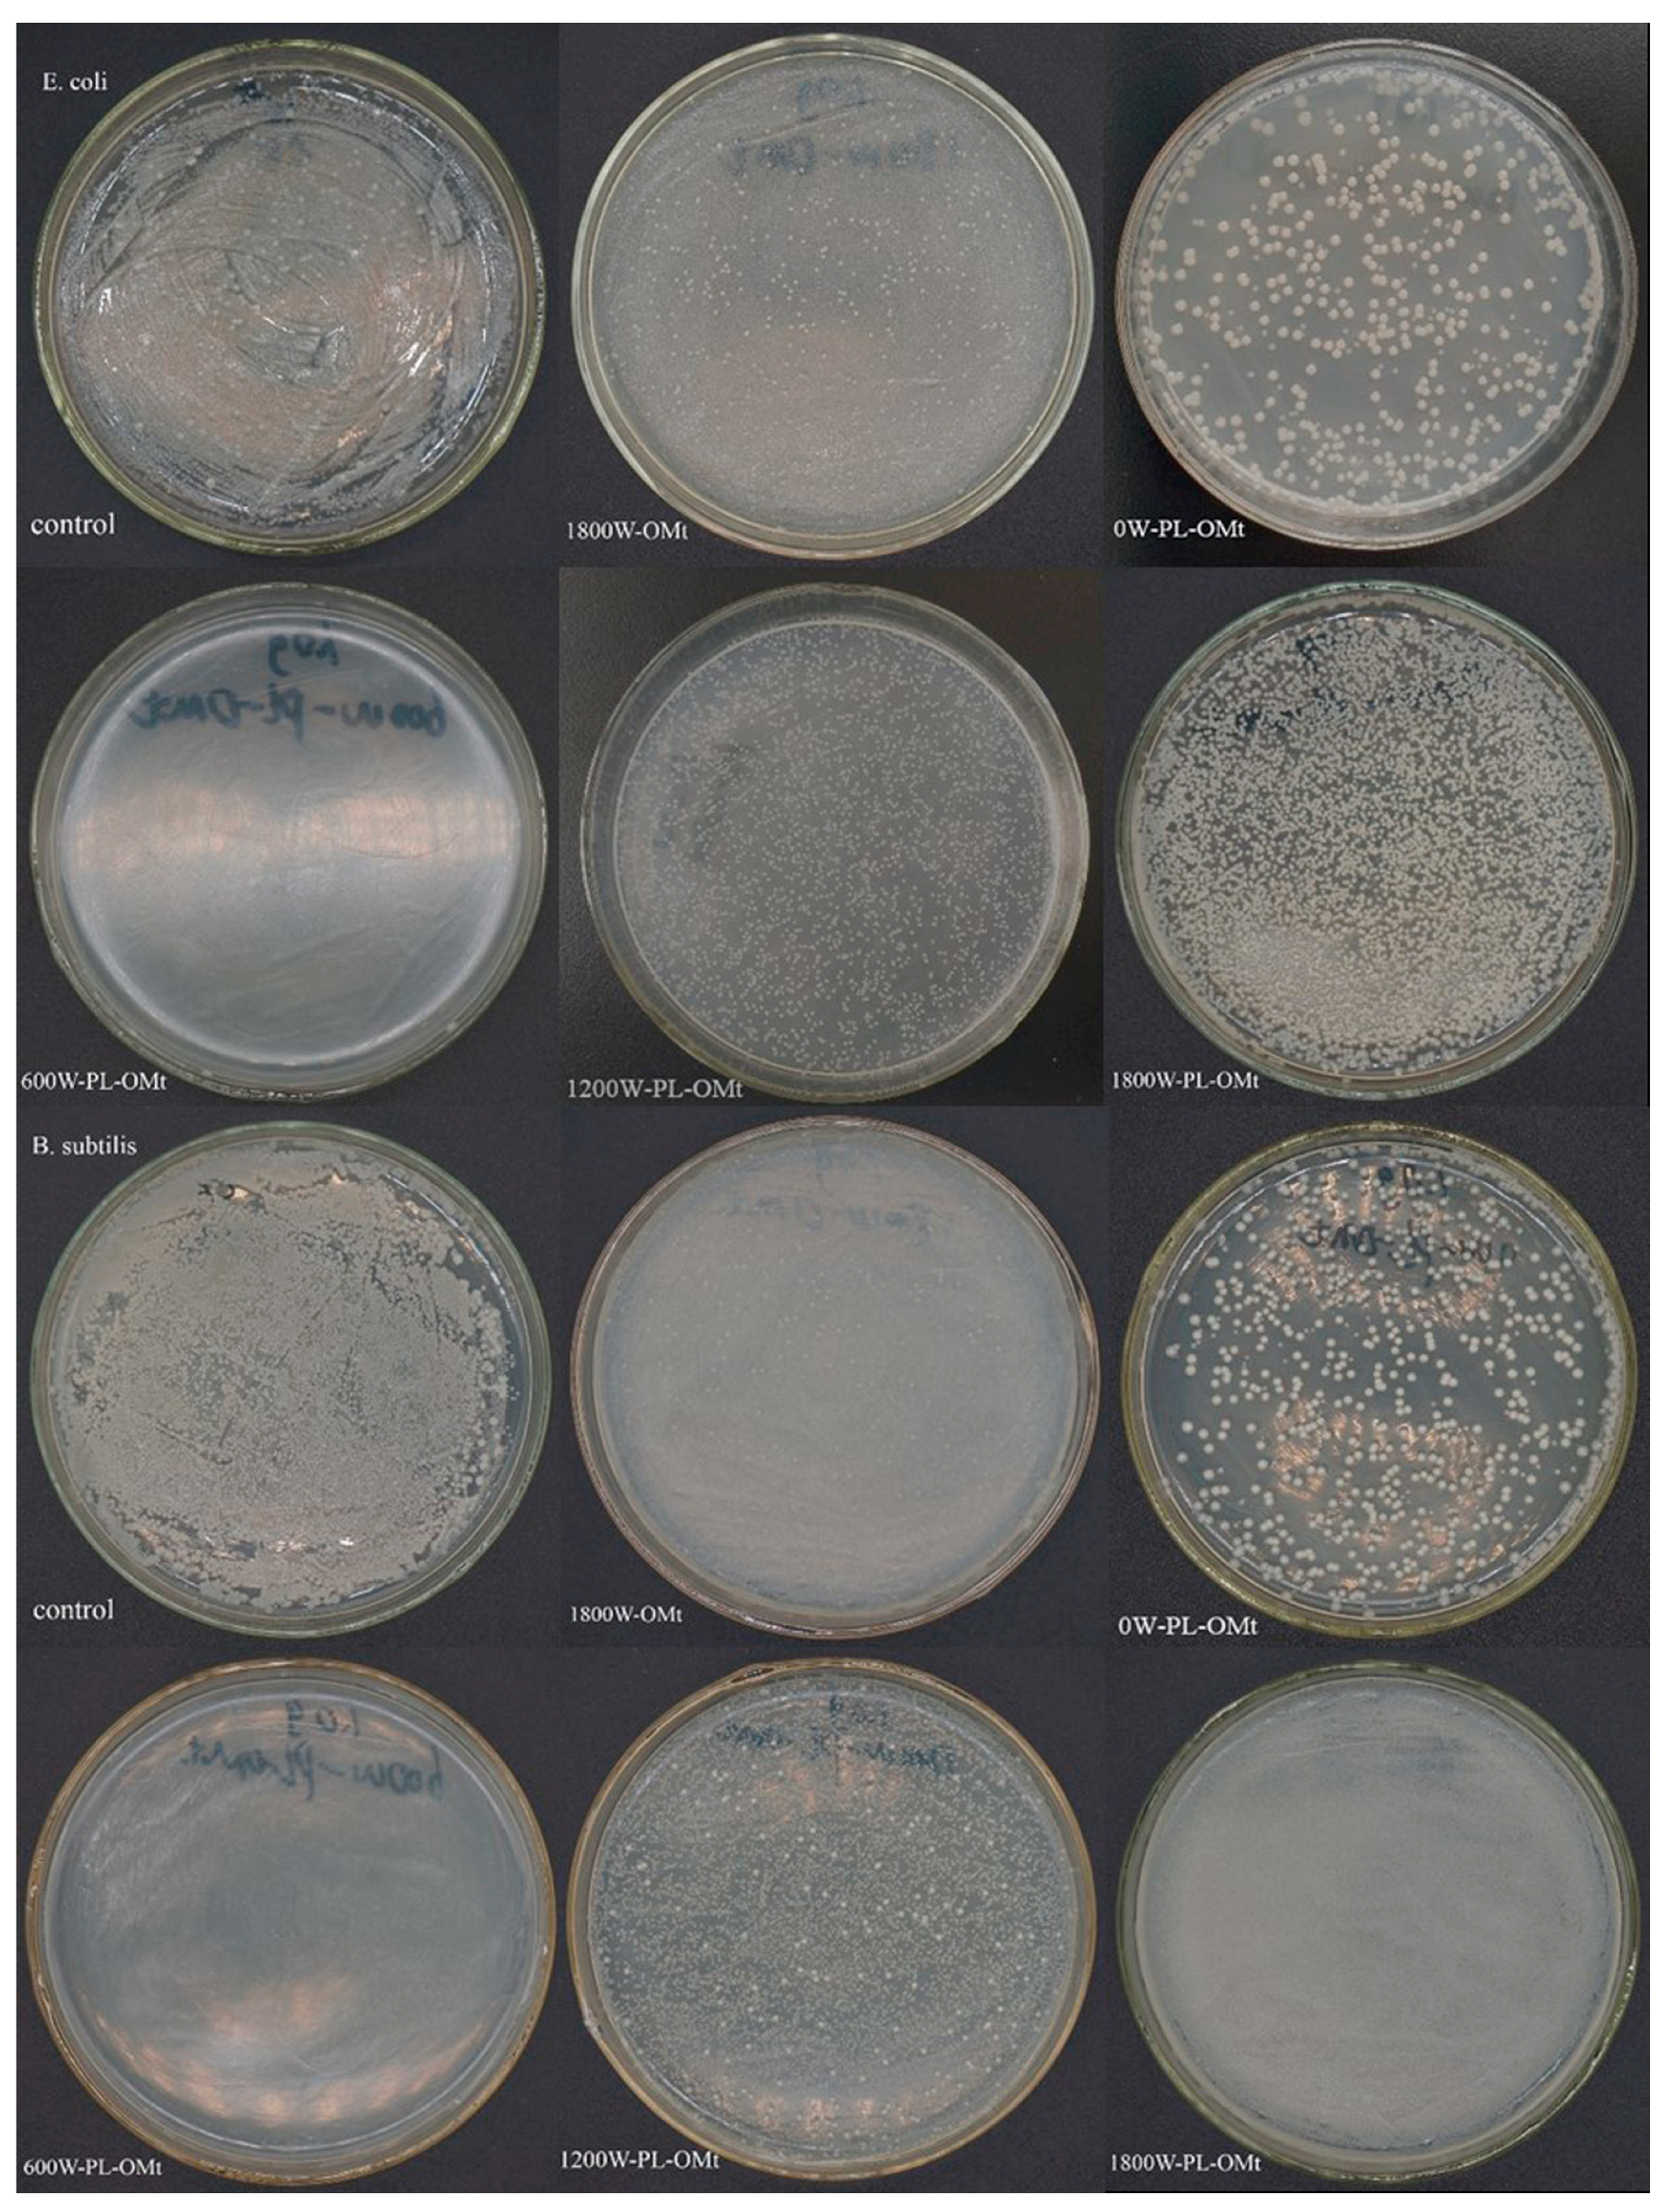
Materials 12 04148 g008 Materials 12 04148 g008

Ultrasound-Assisted Preparation, Characterization, and Antibacterial Activity of Montmorillonite Modified by ε-Polylysine Hydrochloride
Abstract
1. Introduction
2. Materials and Methods
2.1. Materials
2.2. Preparation of PL-Mt
2.3. Preparation of PL-OMt
2.4. X-ray Diffraction (XRD) Analysis
2.5. Particle Size and Distribution of ε-PL
2.6. Fourier Transform Infrared (FTIR) Spectroscopy
2.7. Thermogravimetric Analysis (TGA)
2.8. Determination of Antibacterial Activity of Modified Mt
2.9. Statistical Analysis
3. Results and Discussion
3.1. Characterization of PL-Mt
3.1.1. XRD Analysis of PL-Mt
3.1.2. Determination of Diameters and Distribution of ε-PL in Solutions
3.1.3. FTIR Analysis of PL-Mt
3.1.4. TGA of PL-Mt
3.1.5. Antibacterial Activity of PL-Mt30
3.2. Characterization of PL-OMt
3.2.1. XRD Analysis of PL-OMt
3.2.2. FTIR Analysis of OMt and PL-OMt
3.2.3. TGA of Two Modifiers, OMt, and PL-OMt
3.2.4. Antibacterial Activity of PL-OMt
4. Conclusions
Author Contributions
Funding
Conflicts of Interest
References
- Ling, Y.Z.; Luo, Y.Q.; Luo, J.W.; Wang, X.Y.; Sun, R.C. Novel Antibacterial Paper Based on Quaternized Carboxymethyl Chitosan/Organic Montmorillonite/Ag Np Nanocomposites. Ind. Crop. Prod. 2013, 51, 470–479. [Google Scholar] [CrossRef]
- Liu, S.; Cai, P.; Li, X.; Chen, L.; Li, L.; Li, B. Effect of Film Multi-Scale Structure on the Water Vapor Permeability in Hydroxypropyl Starch (HPS)/Na-MMt Nanocomposites. Carbohydr. Polym. 2016, 154, 186–193. [Google Scholar] [CrossRef] [PubMed]
- Shekarabi, A.S.; Oromiehie, A.R.; Vaziri, A.; Ardjmand, M.; Safekordi, A.A. Investigation of the Effect of Nanoclay on the Properties of Quince Seed Mucilage Edible Films. Food Sci. Nutr. 2014, 22, 821–827. [Google Scholar] [CrossRef] [PubMed]
- Xie, F.W.; Pollet, E.; Halley, P.J.; Averous, L. Starch-Based Nano-Biocomposites. Prog. Polym. Sci. 2013, 38, 1590–1628. [Google Scholar] [CrossRef]
- Gao, W.; Dong, H.Z.; Hou, H.X.; Zhang, H. Effects of Clays with Various Hydrophilicities on Properties of Starch–Clay Nanocomposites by Film Blowing. Carbohydr. Polym. 2012, 88, 321–328. [Google Scholar] [CrossRef]
- Giannakas, A.; Grigoriadi, K.; Leontiou, A.; Barkoula, N.M.; Ladavos, A. Preparation, Characterization, Mechanical and Barrier Properties Investigation of Chitosan-Clay Nanocomposites. Carbohydr. Polym. 2014, 108, 103–111. [Google Scholar] [CrossRef]
- Nouri, A.; Yaraki, M.T.; Ghorbanpour, M.; Agarwal, S.; Gupta, V.K. Enhanced Antibacterial Effect of Chitosan Film Using Montmorillonite/Cuo Nanocomposite. Int. J. Biol. Macromol. 2018, 109, 1219–1231. [Google Scholar] [CrossRef]
- Lavorgna, M.; Attianese, I.; Buonocore, G.G.; Conte, A.; Del Nobile, M.A.; Tescione, F.; Amendola, E. MMt-Supported Ag Nanoparticles for Chitosan Nanocomposites: Structural Properties and Antibacterial Activity. Carbohydr. Polym. 2014, 102, 385–392. [Google Scholar] [CrossRef]
- Makwana, D.; Castaño, J.; Somani, R.S.; Bajaj, H.C. Characterization of Agar-CMC/Ag-MMt Nanocomposite and Evaluation of Antibacterial and Mechanical Properties for Packaging Applications. Arab. J. Chem. 2018. [Google Scholar] [CrossRef]
- Luis, F.G.; Piedrahita, C.; Thein, K. Incorporation of silver in montmorillonite-type phyllosilicates as potential antibacterial material. Curr. Opin. Chem. Eng. 2016, 11, 7–13. [Google Scholar]
- Chang, S.S.; Lu, W.Y.; Park, S.H.; Kang, D.H. Control of Foodborne Pathogens on Ready-to-Eat Roast Beef Slurry by -Polylysine. Int. J. Food Microbiol. 2010, 141, 236–241. [Google Scholar] [CrossRef] [PubMed]
- Hiraki, J.; Ichikawa, T.; Ninomiya, S.; Seki, H.; Uohama, K.; Seki, H.; Kimura, S.; Yanagimoto, Y.; Barnett, J.W. Use of Adme Studies to Confirm the Safety of -Polylysine as a Preservative in Food. Regul. Toxicol. Pharmacol. 2003, 37, 328–340. [Google Scholar] [CrossRef]
- Zahi, M.R.; El Hattab, M.; Liang, H.; Yuan, Q. Enhancing the Antimicrobial Activity of D-Limonene Nanoemulsion with the Inclusion of -Polylysine. Food Chem. 2017, 221, 18–23. [Google Scholar] [CrossRef] [PubMed]
- Zhang, L.; Li, R.; Dong, F.; Tian, A.; Li, Z.; Dai, Y. Physical, Mechanical and Antimicrobial Properties of Starch Films Incorporated with -Poly-L-Lysine. Food Chem. 2015, 166, 107–114. [Google Scholar] [CrossRef]
- Yoshida, T.; Nagasawa, T. -Poly-L-Lysine: Microbial Production, Biodegradation and Application Potential. Appl. Microbiol. Biotechnol. 2003, 62, 21–26. [Google Scholar] [CrossRef]
- Lin, L.; Gu, Y.L.; Cui, H.Y. Novel Electrospun Gelatin-Glycerin-Poly-Lysine Nanofibers for Controlling Listeria Monocytogenes on Beef. Food Packag. Shelf Life 2018, 18, 21–30. [Google Scholar] [CrossRef]
- Ye, R.; Xu, H.; Wan, C.; Peng, S.; Wang, L.; Xu, H.; Aguilar, Z.P.; Xiong, Y.; Zeng, Z.; Wei, H. Antibacterial Activity and Mechanism of Action of -Poly-L-Lysine. Biochem. Biophys. Res. Commun. 2013, 439, 148–153. [Google Scholar] [CrossRef]
- Li, Y.N.; Ye, Q.Q.; Hou, W.F.; Zhang, G.Q. Development of Antibacterial -Polylysine/Chitosan Hybrid Films and the Effect on Citrus. Int. J. Biol. Macromol. 2018, 118 Pt B, 2051–2056. [Google Scholar] [CrossRef]
- Shukla, S.C.; Singh, A.; Pandey, A.K.; Mishra, A. Review on Production and Medical Applications of -Polylysine. Biochem. Eng. J. 2012, 65, 70–81. [Google Scholar] [CrossRef]
- Maji, P.K.; Guchhait, P.K.; Bhowmick, A.K. Effect of Nanoclays on Physico-Mechanical Properties and Adhesion of Polyester-Based Polyurethane Nanocomposites: Structure–Property Correlations. J. Mater. Science. 2009, 44, 5861–5871. [Google Scholar] [CrossRef]
- Patel, H.A.; Shah, S.; Shah, D.O.; Joshi, P.A. Sustained Release of Venlafaxine from Venlafaxine–Montmorillonite–Polyvinylpyrrolidone Composites. Appl. Clay Sci. 2011, 51, 126–130. [Google Scholar] [CrossRef]
- Gao, Y.L.; Dai, Y.Y.; Zhang, H.; Diao, E.J.; Hou, H.X.; Dong, H.Z. Effects of Organic Modification of Montmorillonite on the Performance of Starch-Based Nanocomposite Films. Appl. Clay Sci. 2014, 99, 201–206. [Google Scholar] [CrossRef]
- Chaudhary, D.; Liu, H. Ultrasonic Treatment and Synthesis of Sugar Alcohol Modified Na+-Montmorillonite Clay. Ultrason. Sonochem. 2013, 20, 63–68. [Google Scholar] [CrossRef] [PubMed]
- Zhang, H.; Zhang, J.L.; Gao, Y.L.; Wang, W.T.; Dong, H.Z.; Hou, H.X.; Liu, X.X. Effect of Modification Extent of Montmorillonite on the Performance of Starch Nanocomposite Films. Starch-Starke. 2017, 69, 1700088. [Google Scholar] [CrossRef]
- Jo, Y.; Garcia, C.V.; Ko, S.; Lee, W.; Shin, G.H.; Choi, J.C.; Park, S.; Kim, J.T. Characterization and Antibacterial Properties of Nanosilver-Applied Polyethylene and Polypropylene Composite Films for Food Packaging Applications. Food Biosci. 2018, 23, 83–90. [Google Scholar] [CrossRef]
- Savas, L.A.; Hancer, M. Montmorillonite Reinforced Polymer Nanocomposite Antibacterial Film. Appl. Clay Sci. 2015, 108, 40–44. [Google Scholar] [CrossRef]
- Xu, G.N.; Qiao, X.L.; Qiu, X.L.; Chen, J.G. Preparation and Characterization of Nano-Silver Loaded Montmorillonite with Strong Antibacterial Activity and Slow Release Property. J. Mater. Sci. Technol. 2011, 27, 685–690. [Google Scholar] [CrossRef]
- Zapata, P.A.; Larrea, M.; Tamayo, L.; Rabagliati, F.M.; Azocar, M.I.; Paez, M. Polyethylene/Silver-Nanofiber Composites: A Material for Antibacterial Films. Mater Sci. Eng. C Mater Biol. Appl. 2016, 69, 1282–1289. [Google Scholar] [CrossRef]
- Bujdáková, H.; Bujdáková, V.; Májeková-Koščová, H.; Gaálová, B.; Bizovská, V.; Boháč, P.; Bujdák, J. Antimicrobial Activity of Organoclays Based on Quaternary Alkylammonium and Alkylphosphonium Surfactants and Montmorillonite. Appl. Clay Sci. 2018, 158, 21–28. [Google Scholar] [CrossRef]
- Li, T.; Lin, O.L.; Lu, Z.Y.; He, L.M.; Wang, X.S. Preparation and Characterization of Silver Loaded Montmorillonite Modified with Sulfur Amino Acid. Appl. Surf. Sci. 2014, 305, 386–395. [Google Scholar] [CrossRef]
- Veiskarami, M.; Sarvi, M.N.; Mokhtari, A.R. Influence of the Purity of Montmorillonite on Its Surface Modification with an Alkyl-Ammonium Salt. Appl. Clay Sci. 2016, 120, 111–120. [Google Scholar] [CrossRef]
- Kalaria, D.R.; Sharma, G.; Beniwal, V.; Ravi Kumar, M.N. Design of Biodegradable Nanoparticles for Oral Delivery of Doxorubicin: In Vivo Pharmacokinetics and Toxicity Studies in Rats. Pharm. Res. 2009, 26, 492–501. [Google Scholar] [CrossRef] [PubMed]
- Li, Y.J.; Chen, H.; Wu, J.; He, Q.; Li, Y.T.; Yang, W.B.; Zhou, Y.L. Preparation and Characterization of APTES Modified Magnetic MMt Capable of Using as Anisotropic Nanoparticles. Appl. Surf. Sci. 2018, 447, 393–400. [Google Scholar] [CrossRef]
- Lin, L.; Xue, L.; Duraiarasan, S.; Cui, H.Y. Preparation of -Polylysine/Chitosan Nanofibers for Food Packaging against Salmonella on Chicken. Food Packag. Shelf Life 2018, 17, 134–141. [Google Scholar] [CrossRef]
- Zheng, X.; Dou, J.; Yuan, J.; Qin, W.; Hong, X.; Ding, A. Removal of Cs+ from Water and Soil by Ammonium-Pillared Montmorillonite/Fe3O4 Composite. J. Environ. Sci. 2017, 56, 12–24. [Google Scholar] [CrossRef] [PubMed]
- Shah, K.J.; Mishra, M.K.; Shukla, A.D.; Imae, T.; Shah, D.O. Controlling Wettability and Hydrophobicity of Organoclays Modified with Quaternary Ammonium Surfactants. J. Colloid Interface Sci. 2013, 407, 493–499. [Google Scholar] [CrossRef] [PubMed]
- Zhou, M.; Liu, Q.; Wu, S.S.; Gou, Z.Q.; Wu, X.Y.; Xu, D. Starch/Chitosan Films Reinforced with Polydopamine Modified Mmt: Effects of Dopamine Concentration. Food Hydrocoll. 2016, 61, 678–684. [Google Scholar] [CrossRef]
- Pires, J.; Juźków, J.; Pinto, M.L. Amino Acid Modified Montmorillonite Clays as Sustainable Materials for Carbon Dioxide Adsorption and Separation. Colloid Surf. A Physicochem. Eng. Asp. 2018, 544, 105–110. [Google Scholar] [CrossRef]
- Li, Y.Q.; Han, Q.; Feng, J.L.; Tian, W.L.; Mo, H.Z. Antibacterial Characteristics and Mechanisms of -Poly-Lysine against Escherichia Coli and Staphylococcus Aureus. Food Control. 2014, 43, 22–27. [Google Scholar] [CrossRef]
- Zhu, J.X.; Zhang, P.; Qing, Y.H.; Wen, K.; Su, X.L.; Ma, L.Y.; Wei, J.M.; Liu, H.M.; He, H.P.; Xi, Y.F. Novel Intercalation Mechanism of Zwitterionic Surfactant Modified Montmorillonites. Appl. Clay Sci. 2017, 141, 265–271. [Google Scholar] [CrossRef]
- Zhu, J.X.; Qing, Y.H.; Wang, T.; Zhu, R.L.; Wei, J.M.; Tao, Q.; Yuan, P.; He, H.P. Preparation and Characterization of Zwitterionic Surfactant-Modified Montmorillonites. J. Colloid Interface Sci. 2011, 360, 386–392. [Google Scholar] [CrossRef] [PubMed]
- Bhattacharya, S.; Dineshkumar, R.; Dhanarajan, G.; Sen, R.; Mishra, S. Improvement of -Polylysine Production by Marine Bacterium Bacillus Licheniformis Using Artificial Neural Network Modeling and Particle Swarm Optimization Technique. Biochem. Eng. J. 2017, 126, 8–15. [Google Scholar] [CrossRef]
- Liu, J.H.; Xiao, J.; Li, F.; Shi, Y.; Li, D.P.; Huang, Q.R. Chitosan-Sodium Alginate Nanoparticle as a Delivery System for -Polylysine: Preparation, Characterization and Antimicrobial Activity. Food Control. 2018, 91, 302–310. [Google Scholar] [CrossRef]

| ε-PL Concentration (g/100 mL Water) | Parameters | PDI |
|---|---|---|
| Mean Diameter (nm) | ||
| 1% | 1134.7 ± 53.4 c | 0.211 ± 0.167 a |
| 3% | 1218.5 ± 98.7 c | 0.181 ± 0.102 a |
| 5% | 1413.8 ± 68.8 b | 0.152 ± 0.107 a |
| 7% | 1579.3 ± 21.9 a | 0.146 ± 0.050 a |
| Ultrasonic Power (W) | Interlayer Space (nm) | ||
|---|---|---|---|
| OMt | PL-OMt | Δd | |
| 0 | 3.00 | 3.64 | 0.64 |
| 600 | 3.13 | 3.83 | 0.70 |
| 1200 | 3.13 | 3.66 | 0.53 |
| 1800 | 3.20 | 3.68 | 0.48 |
© 2019 by the authors. Licensee MDPI, Basel, Switzerland. This article is an open access article distributed under the terms and conditions of the Creative Commons Attribution (CC BY) license (http://creativecommons.org/licenses/by/4.0/).
Share and Cite
Yuan, X.; Zhang, J.; Zhang, R.; Liu, J.; Wang, W.; Hou, H. Ultrasound-Assisted Preparation, Characterization, and Antibacterial Activity of Montmorillonite Modified by ε-Polylysine Hydrochloride. Materials 2019, 12, 4148. https://doi.org/10.3390/ma12244148
Yuan X, Zhang J, Zhang R, Liu J, Wang W, Hou H. Ultrasound-Assisted Preparation, Characterization, and Antibacterial Activity of Montmorillonite Modified by ε-Polylysine Hydrochloride. Materials. 2019; 12(24):4148. https://doi.org/10.3390/ma12244148
Chicago/Turabian StyleYuan, Xinfu, Jinli Zhang, Rui Zhang, Jingyuan Liu, Wentao Wang, and Hanxue Hou. 2019. "Ultrasound-Assisted Preparation, Characterization, and Antibacterial Activity of Montmorillonite Modified by ε-Polylysine Hydrochloride" Materials 12, no. 24: 4148. https://doi.org/10.3390/ma12244148
APA StyleYuan, X., Zhang, J., Zhang, R., Liu, J., Wang, W., & Hou, H. (2019). Ultrasound-Assisted Preparation, Characterization, and Antibacterial Activity of Montmorillonite Modified by ε-Polylysine Hydrochloride. Materials, 12(24), 4148. https://doi.org/10.3390/ma12244148





